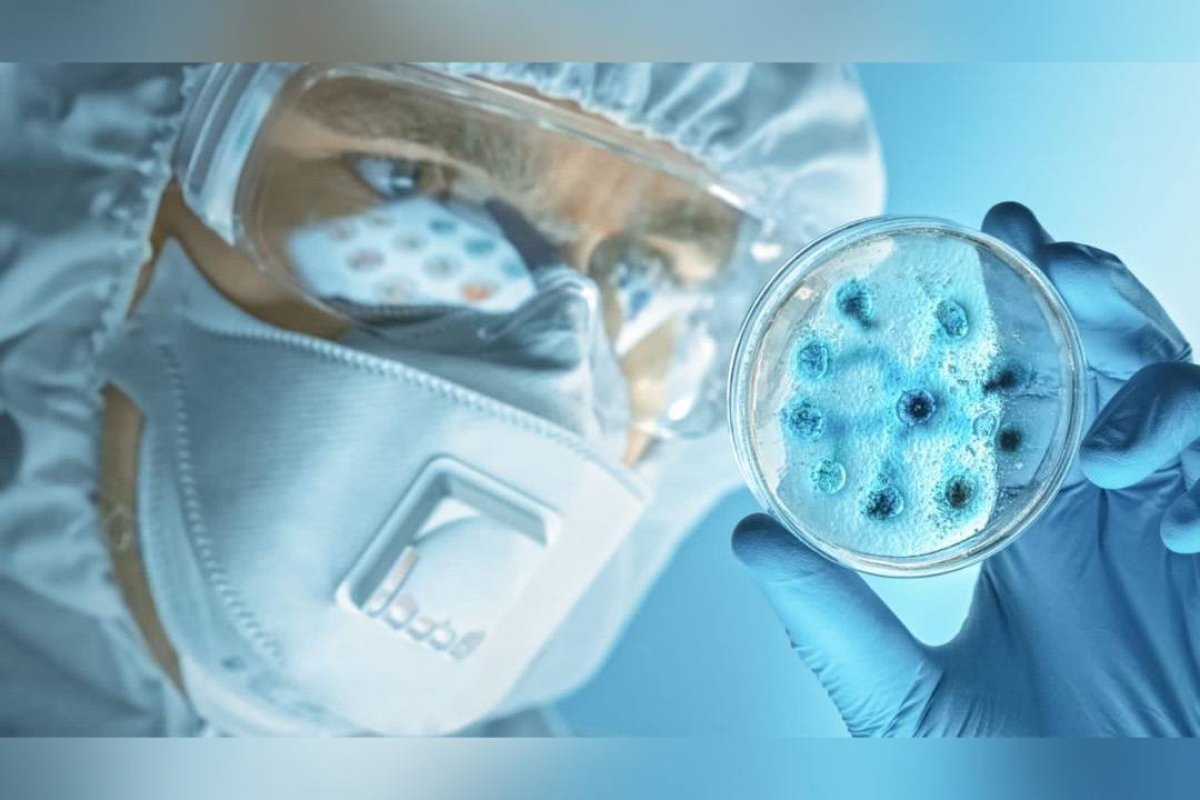

Наша планета настолько густо заселена бактериями и вирусами, что не будь люди и животные такими массивными и заметными, ими можно было бы пренебречь. Собственно, в организме человека и животных собственных клеток гораздо меньше, чем заселяющих нас разнообразных бактерий, большая часть которых нам жизненно необходима, а с патогенными бактериями человек научился бороться при помощи антибиотиков.
Исследуя этих древнейших обитателей, учёные обнаружили, что главными врагами бактерий на протяжении миллиардов лет были и остаются вирусы, и если бы не удивительные механизмы эволюции, бактерии давно бы проиграли вирусам эту войну. Один из таких механизмов – это система распознавания патогенных вирусов и их эффективное уничтожение. Технология, за открытие которой была присуждена Нобелевская премия, получила название CRISPR-Cas. Она представляет собой перенос небольших отрезов вирусной ДНК в геномную структуру бактерии для последующей идентификации этих вирусов и при следующей встречи применение белка Cas-9 для двойного разрыва в цепи вирусной ДНК. Этот белок в популярном изложении называют молекулярными ножницами, поскольку он производит разрезы точно на границах отрезка вирусной ДНК, которую бактерия скопировала себе «на память» для мгновенного узнавания вируса при следующей встрече.
Миссия невыполнима
К сожалению, человек без помощи науки не способен организовать такую генноинженерную атаку с вирусом силами собственного генома, поскольку за десятки тысяч лет существования на Земле эволюция не успела одарить нас такими суперспособностями, как у бактерий. Но попытаться применить данную технологию вырезания кусочка чужой ДНК и встраивания в геном сначала в пробирке, потом на лабораторных животных и, наконец, непосредственно на человеке мировой науке оказалось вполне по силам. Только объектом для разрезания стала не вирусная ДНК, а человеческая. Зачем людям необходимо научиться разрезать собственную ДНК? Всё дело в бесконечных мутациях, которые постоянно происходят во время деления наших клеток. Десятки триллионов клеток нашего организма должны делиться и копировать ДНК друг у друга, не нарушая ту последовательность из шести миллиардов букв, которую заложили нам наши родители еще при зачатии. Задача, согласитесь, невыполнимая.
95% копируется без ошибок, но около 5% постоянно меняются. Далеко не всегда эти случайные изменения несут организму зло. Ведь эволюция человека произошла именно благодаря некоторой изменчивости генов, и если бы не она, мы бы так и жили в каменном веке и высекали огонь каменными орудиями. На самом деле до каменных орудий нашему «предку» тоже нужно было эволюционировать много тысяч и даже миллионов лет – как минимум, выбраться из мирового океана на сушу. Впрочем, нередко в наших клетках происходят и опасные изменения. Точнее сказать, они происходят постоянно, но в большинстве случаев иммунная система их успешно обнаруживает и уничтожает. В случаях, когда иммунная система «проглядела» опасную мутацию, ошибка может пойти в тираж и нанести организму огромный ущерб вплоть до его уничтожения. Многие научные лаборатории во всем мире заняты поиском возможных способов отредактировать ДНК таким образом, чтобы заставить болезнь отступить. Сделать это бывает не так просто, ведь в первые моменты тиражирования (по-научному – репликации ДНК) ничего не предвещает беды, а при появлении симптомов порой бывает уже поздно. Поскольку направление ранней диагностики сбоев организма – это отдельная большая тема, генетики сосредоточили своё внимание на возможностях редактирования или починки ДНК.
Подражая опытным и хитрым бактериям, человек пытается редактировать геном, применяя те самые молекулярные ножницы CRISPR Cas. Успешнее всего получается устранять опасную мутацию (одну!) ещё на стадии эмбриона, когда клеток в организме совсем мало, и можно внедрить в них правильную ДНК без мутации, чтобы она размножалась. Так сегодня уже лечат моногенные заболевания, то есть те, в которых ошибка произошла только в одном гене. К таким заболеваниям относится, например, колбочковая дистрофия сетчатки глаза. Кроме того, при помощи генной инженерии можно лечить такие редкие врожденные моногенные заболевания, как муковисцидоз, талассемия, гемофилия, некоторые формы лейкемии и СМА (спинально-мышечной атрофии).
Три года за смелый эксперимент
Механизм исправления ДНК понятен: ДНК разрезается белком Cas9 в нужном месте, выбрасывается неправильный участок, а внутренняя система в клетке сшивает края цепочки уже без ошибки. В пробирке этот метод отлично работает, но как можно исправить ДНК в триллионах уже пораженных клеток, науке пока неизвестно. Зато достоверно известно и многократно доказано, все подобные поломки вполне излечимы на стадии эмбриона, пока клеток в организме мало. Многие моногенные заболевания являются наследственными, поэтому их можно вовремя предугадать, если сделать генетический тест будущим родителям. Важно при этом понимать, что вариантов сочетаний родительских генов бесконечно много, и заранее предвидеть какую-то патологию невозможно, это всегда лотерея. Но если есть опасность унаследовать страшный диагноз, генетический тест стоит сделать.
Впрочем, генетическое тестирование намного чаще используется для диагностирования взрослых людей, чем для еще не рожденных. Исключение составляет только ЭКО (экстракорпоральное оплодотворение), где такому тестированию при желании можно подвергать все имеющиеся эмбрионы. Хотя зачастую сегодня их отбирают по морфологическим признакам, то есть, проще говоря, по размеру, форме и красоте, почти как помидоры на рынке. И это в 21-м веке, имея все возможности генетического тестирования! – возмущаются специалисты. Отбор лучшего эмбриона с помощью генетического тестирования это не генная инженерия, а, скорее, наоборот – надёжный способ её избежать. Так, в 2018 году китайский учёный Хэ Цзянькуй из Южного научно-технологического университета нарушил закон, отредактировав при отборе эмбрионов для ЭКО ДНК девочек-близнецов, чтобы они не унаследовали от своих родителей ВИЧ-инфекцию и получил за свой смелый опыт гигантский штраф и лишение свободы на три года.
Боимся гмо, а едим пестициды
Применение технологий генной инженерии – это очень тонкая и опасная область, поскольку, как любая новая технология, она может не только спасать, но и вредить. Именно поэтому во многих странах она запрещена не только на людях, но даже на животных и растениях. Например, в России запрещено производство продуктов, содержащих ГМО, что является парадоксальным, ведь ввоз в Россию продуктов, содержащих ГМО, разрешён. Значит, потребитель всё равно употребляет их в пищу, только платит больше, поскольку они импортные. Между тем, одно из важнейших характеристик сельскохозяйственных культур с ГМО, которых добились генетики – это даже не высокая урожайность, не крупные красивые плоды или особенные вкусовые качества, хотя всё это тоже имеет место. Самое ценное достижение генной инженерии в области сельского хозяйства – это конструирование сортов, устойчивых к вредителям, с которыми ещё с середины прошлого века боролись и продолжают сегодня бороться при помощи ядовитых пестицидов. Старшее поколение наверняка помнят аббревиатуру ДДТ, которая расшифровывается как дихлордифенил трихлорметилметан или попросту «дуст». Это инсектицид, опаснейший яд, который в огромных количествах распыляли на полях, убивая на них всё живое. Позднее пестициды научились делать менее токсичными, но их патогенное влияние на человека, животных и природу хорошо известно и многократно доказано, в отличие от ГМО.
Предъявите генетический паспорт!
Продемонстрировав свою высокую эффективность при лечении редких (орфанных) наследственных генетических заболеваний на ранних стадиях, например, препаратом Zolgensma против СМА, она вызвала множество вопросов и нареканий при попытке лечения онкологических заболеваний. Недавние клинические испытания CRISPR-Cas в США показали крайне невысокую эффективность: только у 5-ти пациентов из 16-ти прекратился прогресс заболевания, при этом среди побочных эффектов имели место тяжелые побочные реакции. Что касается препаратов, подавляющих репликацию ДНК в раковых клетках, они широко применяются, но являются высокотоксичными и имеют большое количество побочных эффектов.
В отличие от редактирования генома по технологии CRISPR-Cas, многие другие генетические методы уже давно не являются передним краем науки. Как и все когда-то прорывные, революционные открытия, спустя десять и более лет, они перешли в разряд доступных прикладных технологий. Возможно, полный генетический паспорт пока еще не всем доступен по цене, но полногеномный анализ, как правило, и не требуется, если пациенту известны какие-то заболевания его родителей, бабушек и других родственников. Благодаря генетическим тестам и персонализированной медицине сегодня можно получить все данные о своих предрасположенностях, причем, задолго до того, как они дали о себе знать. Вместо лечения наследственного заболевания сегодня у пациентов есть возможность избежать его или хотя бы значительно отодвинуть по времени. В частности, наследственную семейную гиперхолестеринемию (повышенном уровне холестерина) можно диагностировать задолго до появления тромбов и проблем с работой сердечно-сосудистой системы.

Расщепить миллионы тонн
С помощью методов генной инженерии из природных микроорганизмов ученые сегодня организуют целые производства различных ферментов для многих отраслей промышленности – от медицинских препаратов до лакокрасочных материалов и пищевых продуктов. Ферменты нужны практически во всех областях производства – одни ферменты расщепляют стойкие пятна на одежде, другие позволяют бродить пивному суслу, третьи помогают переваривать тяжелую пищу, четвертые нейтрализуют вредные отходы производства.
Мировой опыт показал, что применение химических методов на производстве не только вредно для окружающей среды, но и в разы дороже, чем использование микроорганизмов с заданными свойствами. Намного выгоднее наладить выпуск необходимых ферментов на основе дрожжевых микроорганизмов, которые способны производить определённый белок в нужных количествах. Одна из самых амбициозных задач, которая стоит сегодня перед всеми отечественными специалистами по генной инженерии – это создание фермента, способного переработать более шести миллионов тонн лигнина – отходов целлюлозно-бумажной промышленности, которые уже много лет хранятся на побережье Байкала и представляют серьёзную опасность для экологии целого региона.
Мария Роговая
Проект «3.14 Будущее наступило» создан при поддержке Министерства науки и высшего образования РФ